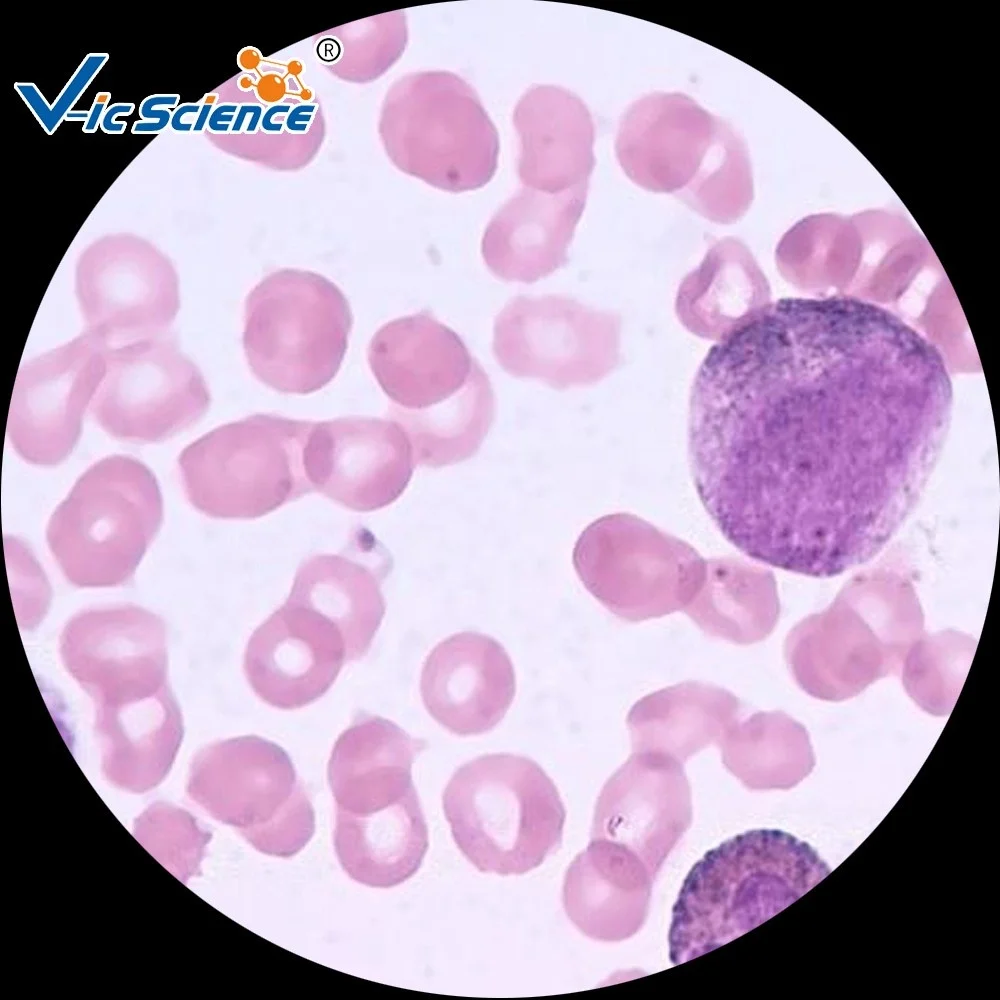
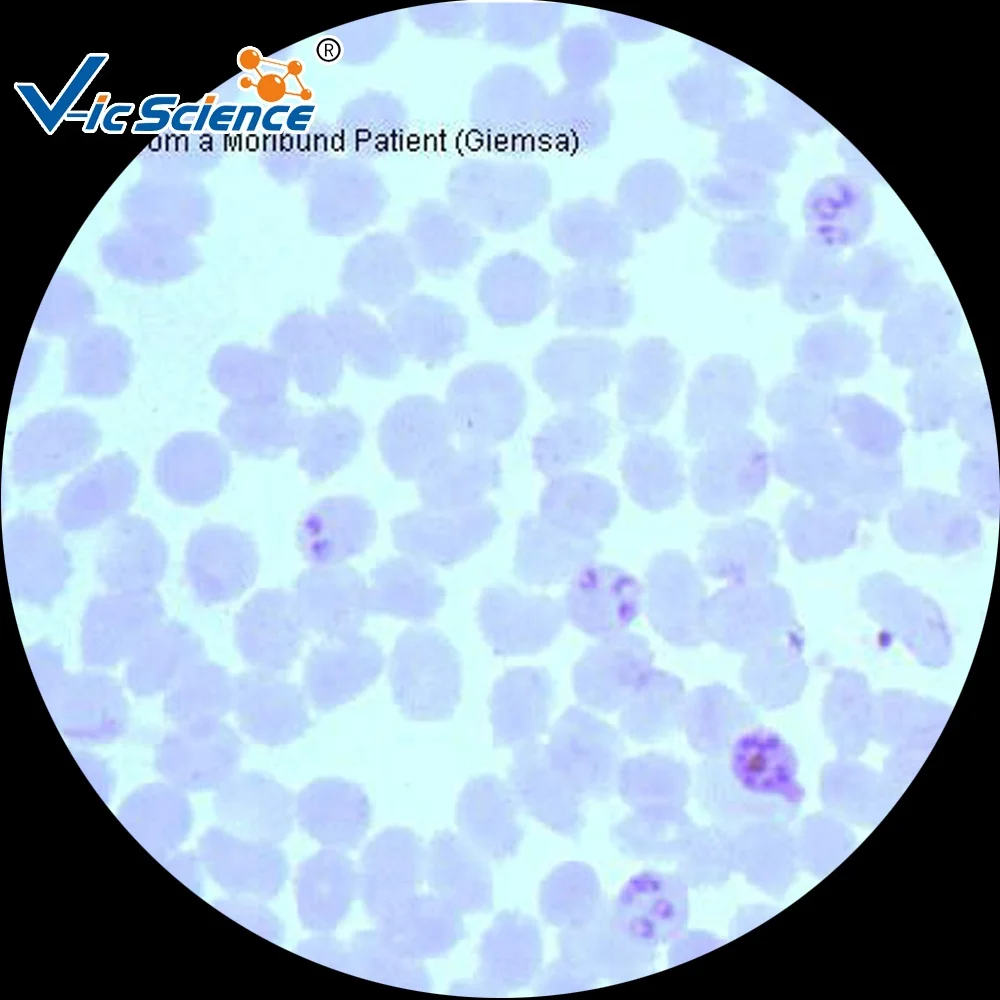

HP051 острый симплициальных аппендицит
HP052 острый флегмонозный аппендицит,
HP053 хронических appendcitis
HP054 фокусное с шаровидным графитом для очищения печени цирроз
HP055 хронический холецистит
HP056 рак пищевода (хорошо различия плоский болезни)
HP057 желудка аденокарцинома (хорошо diff. Трубчатый аденокарцинома)
HP058 Рак кишки (хорошо diff. Трубчатый аденокарцинома)
HP059 гепатоцеллюлярный рак, гцк
HP060 Ходжкина клетки болезни, лимфома, HL
HP061 неходжкинских лимфом
HP062 острый нефрит
HP063 серповидный Гломерулонефрит
HP064 склерозирующий Гломерулонефрит
HP065 острого пиелонефрита
HP066 хронический пиелонефрит
HP067 почек аденокарцинома
HP068 переходное сотовый Рака Мочевого Пузыря
HP069 цервицит
HP070 шейки матки полипом
HP071 шейки матки (плоскоклеточный)
HP072 рака эндометрии
HP073 аденомиоза
HP074 эхинококковой крот
HP075 хориокарцинома
HP076 яичницы cystadenoma
HP077 груди аденофиброма
HP078 Рак молочной железы
HP079 простаты для широкой стопы
HP080 рака предстательной железы
HP081 герминогенные опухоли яичка
HP082 мозга стоимость
HP083 остеосаркома
HP084 милиарного туберкулеза
HP085 сырный пневмонит
HP086 Kindney туберкулеза
HP087 лимфоузлы туберкулеза
HP088 Cutis lepromatous проказы
HP089 тифом кишечника
HP090 острый бактерии диареи
HP091 гнойного менингита
HP092 Тип B эпидемический энцефалит
HP093 острые обычные гепатит
HP094 хронических агрессивной гепатит
HP095 острого тяжелого гепатита
HP096 шистосомоз
HP097 зоба
HP098 токсический зоб (hyper-тиреоидита)
HP099 щитовидная железа аденома
HP100 щитовидная железа рак, сек.
Похожие продукты
![]()
![]()
![]()
![]()
![]()
![]()
![]()
![]()
Упаковка и обслуживание
Упаковка для образовательных человека микроскоп для стоматологов патологическая Гистология подготовлены шлепанцы без задника с открытыми пальцами
С летами опыта экспорта вместе с превосходным качеством, предварительные обслуживания и конкурентоспособные цены, Kingnod завоевала доверие и поддержку многочисленных клиентов. С летами опыта экспорта вместе с превосходным качеством, предварительные обслуживания и конкурентоспособные цены, Kingnod завоевала доверие и поддержку многочисленных клиентов.
![]()
![]()
![]()
Двойная коробка гофрированной бумаги
Ручная упаковка
Прочная и безопасная упаковка
НашиСервис для образовательных человека микроскоп для стоматологов патологическая Гистология подготовлены шлепанцы без задника с открытыми пальцами
1. Отличным сервисным обслуживанием, профессиональный ответ. Мы предоставим Вам лучший выбор ответить база pon 30 лет международной опыт экспорта.
2.100% Прямая продажа с фабрики.
3. При отказе от товара мы специализируемся в обучении и стоматологическое лабораторное оборудование для изготовления.
4. Мы также можем сделать от сырья до готового продукта.
5. Мы работаем по OEM и ODM-наша сильная сторона.
Посмотр производство
![]()
Сильные преимущества для образовательных человека микроскоп для стоматологов патологическая Гистология подготовлены шлепанцы без задника с открытыми пальцами
1. Под микроскопом микробиологии шлепанцы без задника с открытыми пальцами: структура и чёткие и в комплекте, вы можете легко найти характеристики, которые вы хотите.
2. Материал и образца микробиологии шлепанцы без задника с открытыми пальцами, они все свежие, с помощью специальной обработки и достичь наблюдать эффект идеально.
3. Пятно микробиологии шлепанцы без задника с открытыми пальцами: гематоксилином и eosin окрашивания серебро окрашивания и т. д.; Мы также можем использовать специальные окрашивания в соответствии с вашим требованием.
4. Микроскоп шлепанцы без задника с открытыми пальцами; Размеры микробиологии шлепанцы без задника с открытыми пальцами: размер в соответствии с общим circumstances76.2 * 25,4 * (1,0-1,2) мм, стандарт ЕС или пластик, вы также можете чувствовать себя свободно, чтобы выбрать 710171027103710471057105-1710671077107-1,7108,7109,7110,7111 и т. д.
5. Детальные продукты этикетки микробиологии шлепанцы без задника с открытыми пальцами крепится на одной стороне, этикетка, шрифт с красного, черного и синего цвета. Ярлыки имеют прозрачный или непрозрачный, вы можете чувствовать себя свободно, чтобы выбрать. Стильный дизайн.
Наша компания
![]()
![]()
![]()
![]()
1)Xinxiang Vic наука и образование обратную связь о том, что вы хотите, Ltd, основанная в 2003, рядом с Желтой реки и дикий бык Zhengzhou аэропорта. После неустанных усилий, мы никогда не стала известной учебного оборудования Сделано в Китае, которая интегрирует исследованиями, производством и продажами.
В настоящее время, наш биологический подготовлены шлепанцы без задника с открытыми пальцами содержит следующие типы: ботаника, зоология, микробиологии, эмбриологии, гистология, клеточной биологии и генетики, патологические гистология, медицинская паразитология, лекарственное растение biologies, минерал, шлепанцы без задника с открытыми пальцами, совместный анализ гематологических химических веществ шлепанцы без задника с открытыми пальцами,
Флуоресценции шлепанцы без задника с открытыми пальцами, 12 групп более чем четыре тысячи видов. Вы можете чувствовать себя свободно, чтобы выбрать Предпочитаемая вами.
| Тип | Кол-во | Тип | Кол-во |
| Ботаника | 532 различные предметы | | 306 различные предметы |
| Зоология | 188 различные предметы | Клеточной биологии и генетики | 37 разные предметы |
| Микробиологии | 31 разные предметы | Фармацевтические биологии | 217 различные предметы |
| Гистология и эмбриология | 181 различные предметы | Медицинский возбудителя классов | 26 различных предметов |
| Эмбриология | 28 различных предметов | Иммунология | 7 различных предметов |
| Гистология патологий | 165 различные предметы | Анализа крови | 35 различных деталей |
| Медицинская паразитология | 78 различные предметы | Животное для стоматологов патологическая Гистология | 45 разные предметы |
И клубы; Профессиональный опыт: 10 + опыт экспорта.
И клубы; Хорошая натуральных материалов:
(A): научно была проверена и высокое качество биологических материалов.
Ширина (b): высокое качество скольжения стекла и покровные.
(C): импорт химических веществ для фиксации и окрашивания.
(D): точно нужное время взять процесса окрашивания, крепления, сушка.
(E): Мы считаем, что старинная как искусства.
Сертификаты
![]()
![]()
![]()
На лицензия на ведение коммерческой деятельности
Китайского Совета по продвижению международной торговли китайская палата международной торговли
Трансграничной электронного бизнеса сертификат
![]()
![]()
Хэнань образования Ассоциации индустрии оборудования
Китай (материк) образование Ассоциации индустрии оборудования
Иностранной валюты
![]()
Вопросы и ответы
| 1: в течение какого срока вы можете выполнить Заказ обычно?
Как правило, мы будем оказывать сопроводительную, на Возраст 3-15 дней для того чтобы произвести новые шлепанцы без задника с открытыми пальцами, все они основаны на качество на первом месте .. |
| 2: какое у вас Минимальное количество заказа?
Наш минимальный объём заказа составляет 100, как обычно, цена будет выше, если вы закажете только 1.
|
| 3: в течение какого срока при транспортировке?
Время зависит от способа доставки. Это зависит от страны, транспорт, почти в течении 3-7 рабочих дней. |
| 4: какие виды доставок вы?
Обычно мы отправляем товар по воздуху, заказы меньшего размера самое лучшее для того чтобы выбрать международной экспресс-доставки, такие как DHL, TNT, FEDEX,EMS,UPS,TNT,Aramex, которые были бы лучше для Ближний Восток и т. д. Большие заказы подходят для доставки по морю. |
| 5: какие у вас условия оплаты и способ оплаты вы можете принять?
30% T/T заранее, баланс оплаты банковского перевода перед отправкой.
T/T,Western union,Money gram, а также с помощью Master card,Escrow,Paypal, Western union и т. д .. |
| 6: где находится ваша компания?
Наша компания расположена в городе Синьсян, Хэнань, Province,China.
|
| 7: Можете ли вы предоставить мне образцы?
Да, но как можно быстрее образцов не должны покрываться за счет, мы возвратим стоимость образцов после того, как вы сделаете твердый заказ. |
| 8: Можете ли вы сделать OEM & ODM для моего ребенка?
Да, мы предлагаем обслуживание OEM & ODM, а так же мы можем сделать специальные услуги по шлепанцы без задника с открытыми пальцами детали и коробки, ваш логотип, возможно, цвет, возможно, различным дизайном, все зависит от вас. |
| 9: Можете ли вы предоставить другие товары для меня?
Никаких проблем, наши главные продукты готовы шлепанцы без задника с открытыми пальцами, микроскоп стеклянные шлепанцы без задника с открытыми пальцами, покровные, колбонагреватель, микротомы, принадлежности для микроскопа, биологических образцов, учебные модели эксперимент материалов. |
| 10: ок, последняя новинка, есть ли у вас послепродажный сервис?
У нас есть, и мы делаем очень хорошо во время заказа время многие срочный ответ и вызова; Мы можете ли вы поставить колесные цилиндры 1 год после продажное обслуживание. И свяжитесь с нами, если у вас возникают какие-либо сложности или вопросы.
|
![]()
![]()
Добро пожаловать, свяжитесь с нами!
Данные ресурс не является интернет-магазином, а лишь содержит ссылки на международную торговую площадку Alibaba.com